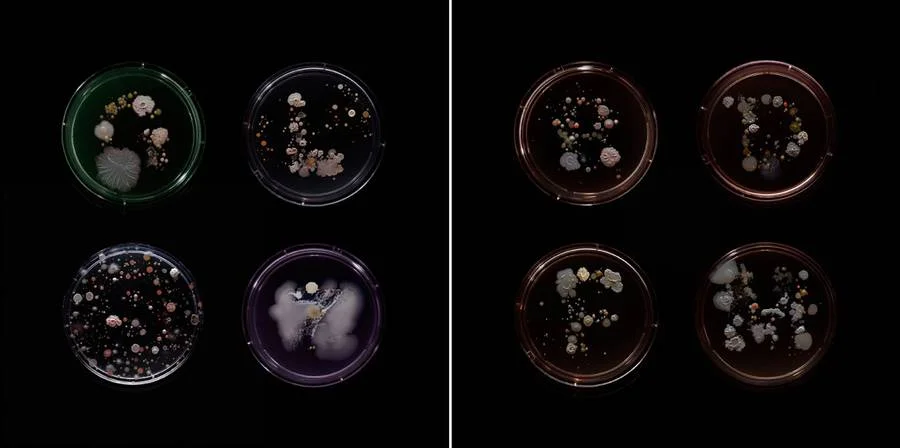
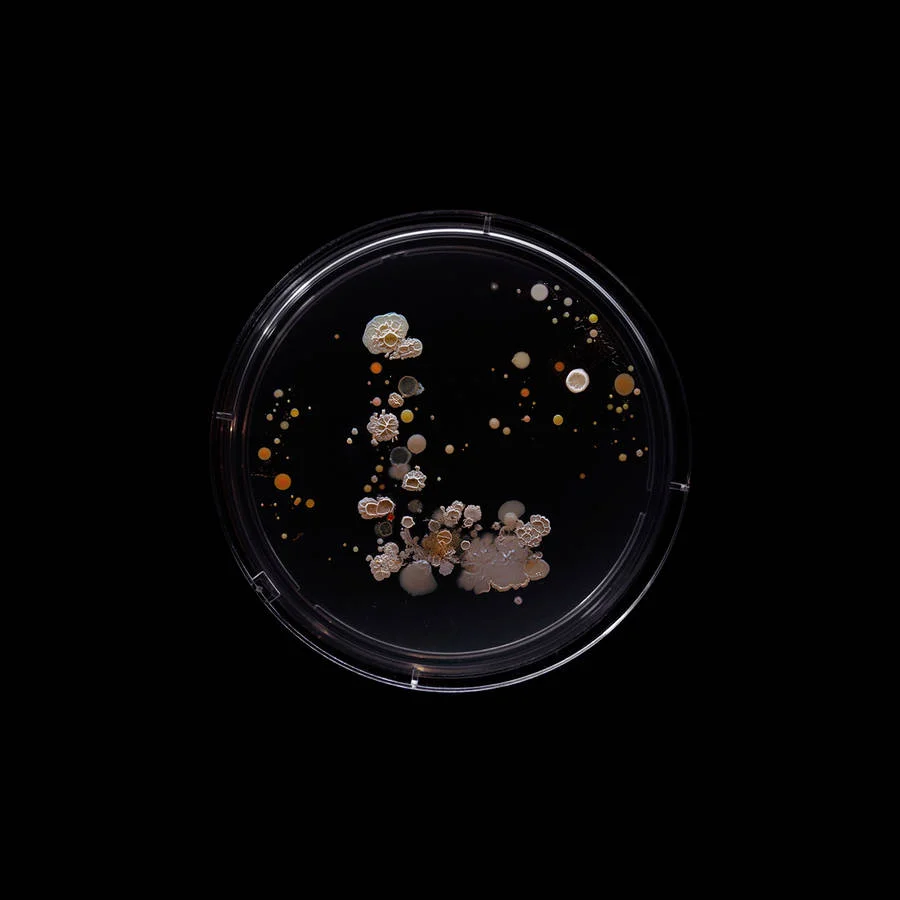

foto di Craig Ward
L’idea ricorda quella della manifestazione Agar Art ma il risultato è ben diverso. Essenziale e decorativo, il lavoro del designer inglese Craig Ward, tramuta davvero i vetrini in opere d’arte.
Nell’estate del 2015 Craig Ward ha viaggiato su ognuna delle 22 linee della metropolitana di New York (dove attualmente vive). Portando con se delle spugne sterili, della forma del numero o della lettera, che contraddistinguevano la linea in cui, di volta in volta, raccoglieva campioni batterici. A questo punto bastava schiacciare le spugne sui vetrini e lasciare tutto in incubazione, per almeno una settimana. E, naturalmente fotografare il risultato.
Gli scatti nati da questo progetto sono stupefacenti. I colori e le forme dei batteri su fondo nero risaltano e richiamano alla mente antiche decorazioni floreali oltre a forme di vita sottomarina. Secondo Craig Ward, questa serie di immagini, dovrebbe essere un inconsueto ritratto della città di New York. E un modo per ricordarci che il mondo che noi percepiamo è molto più limitato di quello in cui realmente viviamo. (via Fubiz)
foto di Craig Ward
foto di Craig Ward
foto di Craig Ward
foto di Craig Ward
foto di Craig Ward